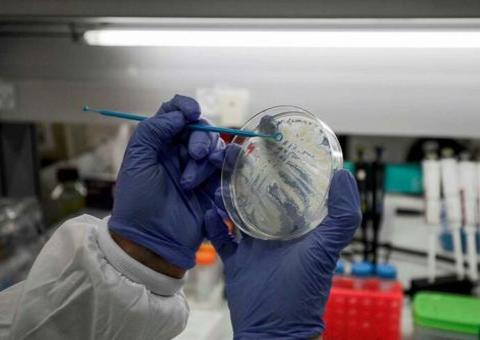
Israel anuncia descoberta de anticorpo para o coronavírus

Envie
LISBOA, PORTUGAL (FOLHAPRESS) - Após um mês e meio com boa parte do setor de comércio e serviços de portas fechadas, Portugal começou, nesta segunda-feira (4), um processo gradual de reabertura econômica. E o primeiro destino pós-confinamento para muitos portugueses foi o mesmo: o cabeleireiro. Proprietário da centenária Barbearia Oliveira, no centro de Lisboa, e de outros três salões na capital, Bruno Oliveira diz que não há mais vagas disponíveis em seus estabelecimentos até o fim da semana. "Só hoje de manhã já foram mais de cem ligações [de clientes]", contou o empresário, enquanto recusava uma chamada para conseguir conversar com a reportagem. A situação nos salões tem sido parecida em todo o país, com um grande fluxo de clientes ávidos por cortes, retoques de coloração e outros serviços. Os cabeleireiros --assim como a maior parte do setor de comércio e serviços-- foram obrigados a encerrar suas atividades em 18 de março, quando Portugal decretou estado de emergência. Com os casos de infecção pela Covid-19 sob controle, Portugal optou por reduzir um nível na escala de atenção. O estado de emergência acabou no sábado (2), sendo substituído pelo de calamidade pública, mais brando. Com isso, o governo divulgou um plano gradual de reabertura econômica, inicialmente dividido em três fases, cujos avanços podem ser interrompidos em caso de uma eventual piora na situação. Na primeira etapa, a partir desta segunda, o "home office" segue como orientação para as empresas, mas alguns setores já foram autorizados a reabrir, embora com restrições de horário e normas mais rígidas de lotação e higiene. De agora em diante, o uso de máscaras passa a ser obrigatório para andar em transportes públicos e entrar em estabelecimentos comerciais. No primeiro dia com as regras em vigor, na estação do metrô do Cais do Sodré, centro de Lisboa, seguranças e policiais se esforçavam para explicar as regras e barrar quem não estava usando a proteção. Na porta dos supermercados, a situação se repetia. "Mas onde é que eu vou comprar uma máscara? O governo vai pagar? Na farmácia, custa um balúrdio [muito caro] e a minha aposentadoria não dá para isso", queixava-se Maria Celeste Rodrigues, 74, ao ser impedida de fazer compras por não ter o equipamento. A percepção da aposentada parece estar de acordo com a realidade. Pesquisas de preço indicam que o valor cobrado para itens como máscaras, géis de limpeza, luvas e desinfetantes chegou, em alguns casos, a aumentar 300%. Para comerciantes e empresas, que passam agora a ter de usar uma série de equipamentos de proteção e higiene adicionais, essas despesas representam um desafio no cenário de crise econômica. "Nós tivemos de reduzir à metade da capacidade a ocupação da barbearia. Temos seis cadeiras, mas só podemos atender a três clientes de cada vez. Além disso, a capa [de proteção para o cabelo não cair na roupa] é descartável. Os profissionais usam máscara e viseira. Temos álcool e desinfetante para clientes e funcionários. São mais custos e menos ganhos", disse Oliveira. Livrarias, concessionárias e lojas de rua de até 200 m² também puderam reabrir, mas com lotação máxima restringida, distanciamento obrigatório de 2 m entre os clientes e obrigação de ter medidas de desinfecção e higiene reforçadas. Vários serviços públicos e cartórios também retornaram, mas com atendimento por agendamento prévio. Mesmo com a reabertura, vendedores se queixavam que, com as fronteiras fechadas para turistas e com os portugueses com medo de gastar dinheiro, apenas voltar ao funcionamento não adiantava muita coisa. De acordo com os planos divulgados com o governo, há mais duas fases previstas de reabertura. Restaurantes, pastelarias e cafés, que atualmente só podem funcionar para entrega em domicílio ou retirada, poderão reabrir em 18 de maio, mas com apenas 50% da capacidade e até as 23h. Em 1º de junho, shoppings serão liberados. Cinemas e teatros também vão reabrir, mas com lotação reduzida, lugares marcados e obrigação de distanciamento. O campeonato de futebol será retomado a partir de 30 de maio, mas os jogos acontecerão sem público.
Artigos relacionados
Últimas notícias
Artigos relacionados